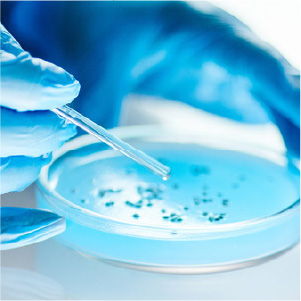

News

「東梅田駅」より徒歩2分の好立地。
患者さまに安心と信頼をお届けすることが、私たちの使命です。
当クリニックでは、患者さま一人ひとりの健やかな未来を第一に考え、最先端の糖尿病・がん免疫療法・幹細胞をはじめとする再生医療治療を提供しています。
安全性・科学的根拠を重視し、専門医チームが最適な治療プランをご提案。
患者さまに安心と信頼をお届けすることが、私たちの使命です。
皆さまの健康をサポートできることを心より願っております。



大阪梅田セリーフクリニックが選ばれる理由
1
点滴×局所注射
全身のお悩みを解決!
糖尿病や動脈硬化症をはじめとする全身的疾患に対する点滴治療と、顔・膝・陰茎など局部的疾患に対する局所注射治療を、自在に組合せて同時にご提供します。
2
業界が注目! 次世代の
幹細胞培養上清液治療
日本再生医療学会推奨の培養液!
極めて安全性が高いオリジナル乳歯歯髄由来幹細胞培養上清液を製造し、月間2,000㎖を超える圧巻の治療実績を維持しています。
3
時代を先取りする
新療法に挑戦!
世界的に研究途上の糖尿病再生医療のノウハウを確立し年間100件以上の治療実績を達成。
業界に先駆けて陰茎海綿体に対する幹細胞を用いたED再生治療にも挑戦しています。

当院の診療内容

大阪梅田セリーフクリニック 院長
近藤 恭士
Kondo Yasushi
日本の再生医療の最前線で活躍し、長年にわたり京都大学iPS細胞研究所(CiRA)に所属していた。
上海での研究を含め研究成果を多数発表し論文の執筆も行っている。
今後、日中両国における影響力を背景に海外の糖尿病患者を対象とした糖尿病再生医療プロジェクトを展開する計画である。
経歴
京都大学 医学博士(糖尿病・栄養内科学)
糖尿病に対するiPS細胞研究に従事
糖尿病、内分泌、栄養代謝、再生医療の専門家
日本内科学会 認定医・専門医
日本糖尿病学会 専門医
日本再生医療学会 会員
元上海根本生物株式会社 医療技術所長
元上海同済大学第十人民医院 iPS研究所長
ルイ・パストゥール医学研究センター 創薬研究室 主任研究員

大阪梅田セリーフクリニック
電話番号
06-6948-5230
住所
〒530-0057
大阪府大阪市北区曽根崎2-7-4
M.VOLANTE UMEDA 5F・6F
診療時間
月曜日~金曜日
※完全予約制
オンライン診療
専門外来 / オンライン診療
(オンライン診療は適時対応)
診療科目
内科・糖尿病内科・脳神経内科・脳神経外科・腫瘍内科・アンチエイジング・自由診療
アクセス
「東梅田駅」より徒歩2分
阪神本線「大阪梅田駅」より徒歩5分
JR「北新地駅」より徒歩5分
JR「大阪駅」より徒歩10分
協力医院
医療法人仁結会
山下医院 → ホームページはこちら